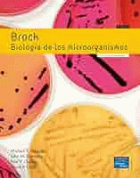

Results
|
|
81.
|
Image from Google Jackets
|
|
|
|
82.
|
Image from Google Jackets
|
|
|
|
83.
|

Local cover image
Image from Google Jackets
|
Ingeniería de control moderna / Ogata, Katsuhiko [texto] by
Edition: 5a ed.
Material type:  Text Text
Publication details: España ; Pearson Educación S.A. , 2010
Availability: Items available for reference: Biblioteca de la Facultad de Tecnología y Cs. Aplicadas : No para préstamo (1).
|
|
|
84.
|
Image from Google Jackets
|
Química : / Brown, Theodore L. by
Edition: 11a ed.
Material type:  Text Text
Publication details: Mx ; Pearson Educación , 2009
Availability: Items available for loan: (1).
|
|
|
85.
|

Local cover image
Image from Google Jackets
|
Física Universitaria : Volumen 1 Hugh D. Young, Roger A. Freedman, Lewis A. Ford by
Edition: 12a ed.
Material type:  Text; Format:
regular print Text; Format:
regular print
Language: Spanish
Publication details: México Pearson Educación , 2009
Availability: Items available for loan: Biblioteca de la Facultad de Ciencias Exactas y Naturales (1). Items available for reference: Biblioteca de la Facultad de Ciencias Exactas y Naturales: No para préstamo (1). Not available: Biblioteca de la Facultad de Ciencias Exactas y Naturales: In transit (6).
|
|
|
86.
|

Local cover image
Image from Google Jackets
|
|
|
|
87.
|
Image from Google Jackets
|
|
|
|
88.
|
Image from Google Jackets
|
|
|
|
89.
|
Image from Google Jackets
|
|
|
|
90.
|

Local cover image
Image from Google Jackets
|
|
|
|
91.
|
Image from Google Jackets
|
|
|
|
92.
|
Image from Google Jackets
|
Fisica : / Wilson, Jerry D. by
Edition: 6a ed.
Material type:  Text Text
Publication details: México ; Pearson Educación , 2007
Availability: Items available for loan: (1).
|
|
|
93.
|

Local cover image
Image from Google Jackets
|
|
|
|
94.
|
Image from Google Jackets
|
|
|
|
95.
|
Image from Google Jackets
|
|
|
|
96.
|
Image from Google Jackets
|
Química Física : / Engel, Thomas by
Edition: 1a ed.
Material type:  Text Text
Publication details: Madrid ; Pearson Educación , 2006
Availability: Items available for loan: (1).
|
|
|
97.
|
Image from Google Jackets
|
|
|
|
98.
|
Image from Google Jackets
|
Topología : / Munkres, James R. by
Edition: 2a ed.
Material type:  Text Text
Publication details: Madrid ; Pearson Educación , 2002
Availability: Items available for loan: (1).
|
|
|
99.
|
Image from Google Jackets
|
|
|
|
100.
|
Local cover image
Image from Google Jackets
|
Sistemas de control en tiempo discreto / Ogata, Katsuhiko [texto] by
Edition: 2a ed.
Material type:  Text Text
Publication details: Mexico ; Pearson Educación , 1996
Availability: Items available for loan: Biblioteca de la Facultad de Tecnología y Cs. Aplicadas (2). Items available for reference: Biblioteca de la Facultad de Tecnología y Cs. Aplicadas : No para préstamo (1).
|